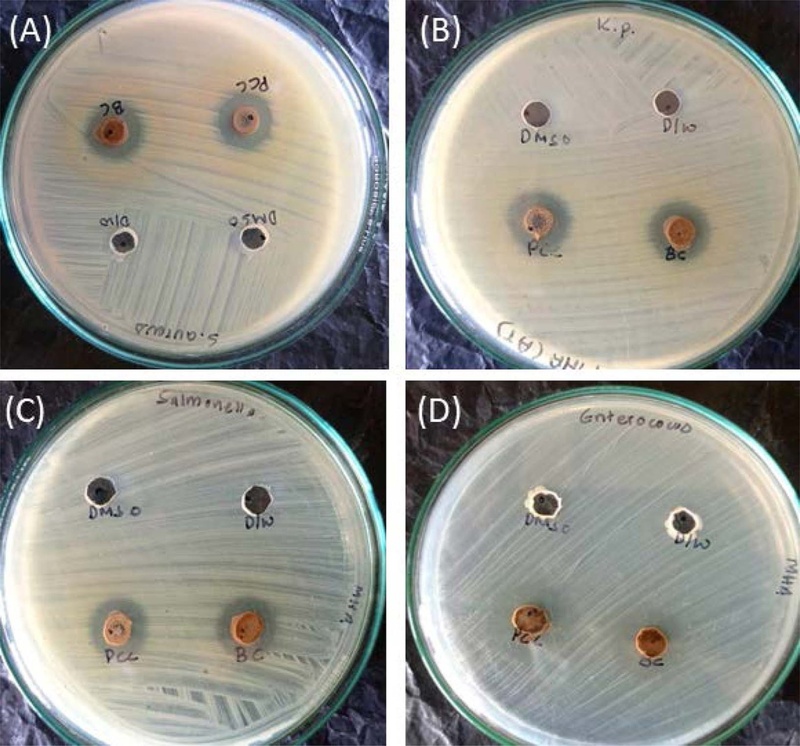

| Home | About the Journal | Browse Archives | Instructions for Authors | Instructions for Reviewers |
-
NPS
Natural Product Sciences
KCI & SCOPUS Journal
-
pISSN 1226-3907 / eISSN 2288-9027
Sorry.
You are not permitted to access the full text of articles.
If you have any questions about permissions,
please contact the Society.
ņŻäņåĪĒĢ®ļŗłļŗż.
ĒÜīņøÉļŗśņØĆ ļģ╝ļ¼Ė ņØ┤ņÜ® ĻČīĒĢ£ņØ┤ ņŚåņŖĄļŗłļŗż.
ĻČīĒĢ£ Ļ┤ĆļĀ© ļ¼ĖņØśļŖö ĒĢÖĒÜīļĪ£ ļČĆĒāü ļō£ļ”Įļŗłļŗż.
Current Issue
Volume 32(1); March 2026
-
Eun-Mi Ahn, Jaehoon Bae
Oolonghomobisflavan B (OHBFB) is a prominent and specific polyphenolic constituent of oolong tea. We previously identified a cell membrane receptor for OHBFB an...
-
Achyut Adhikari, Prajwal Acharya, Prabina Shrestha, Karuna Bajracharya, Kapil Aryal, Sajan Lal Shyaula, Amit Jaisi
The extraction of essential oil can be done in several ways, with some emphasizing quality and others emphasizing quantity. Essential oil components of and we...
-
Rackhyun Park
Skeletal muscle atrophy is closely associated with oxidative stress-induced inflammatory responses, which lead to the activation of catabolic pathways and the l...
-
Irfan Yunianto, Haris Setiawan, Dewi Nurul Istiqomah
Continuous exposure to cigarette smoke causes oxidative stress, leading to diseases in the respiratory tract. Secang ( L.) wood is a popular herbal drink in Ind...
-
Ngoc Khanh Vu, Chang Jung Kim, Soo Min Kim, Young Jun Kim, Kyeong Seon Lee, Ki Yong Lee
(Thunb.) Makino is a deciduous tree commonly distributed in East Asia. Several investigations have documented the biological activity of extracts of this speci...
-
Microenvironment-Driven Modulation of A2E Photoreactivity and Fluorescence Under Blue Light
Deepak Basyal, Shiva Kumar Bhandari, Hye Jin Kim
A2E, a major pyridinium bisretinoid component of retinal lipofuscin, functions as a photosensitizer that undergoes blue light-induced oxidation, contributing to...
-
Nitric Oxide Production Inhibitory Terpenylated Coumarins from Ailanthus altissima
Beom Kyun An, Jae Sang Han, Joon Su Jang, Yong Beom Cho, Mi Kyeong Lee, Bang Yeon Hwang
LC-MS/MS-based molecular networking was used to guide the targeted isolation of terpenylated coumarins from the barks of . Five known terpenylated coumarins (ŌĆō)...
-
Manh Tuan Ha, Trong Trieu Tran, Thu Huong Tran, Seung Eui Min, Sang-Jin Park, Kang-Hyun Han, Jungmoo Huh, Jeong Ah Kim, Byung Sun Min
Phytochemical investigation of the water extract and alkaloid fraction of L. led to the isolation of one new methoxyflavonoid rutinoside (), together with elev...
-
Manh Tuan Ha, Trong Trieu Tran, Thu Huong Tran, Jungmoo Huh, Jeong Ah Kim, Byung Sun Min
(Nakai) Kitagawa belongs to the family Apiaceae (Umbelliferae) and is a perennial herb naturally endemic to Ulleung Island, Republic of Korea. Following its su...
-
Thi Nguyet Anh Dinh, Dong Hoon Shin, You Mie Lee, Jeong Ah Kim
L. has been widely used in traditional medicine and is known to contain bioactive ellagitannins with potential antidiabetic properties. The primary objective o...